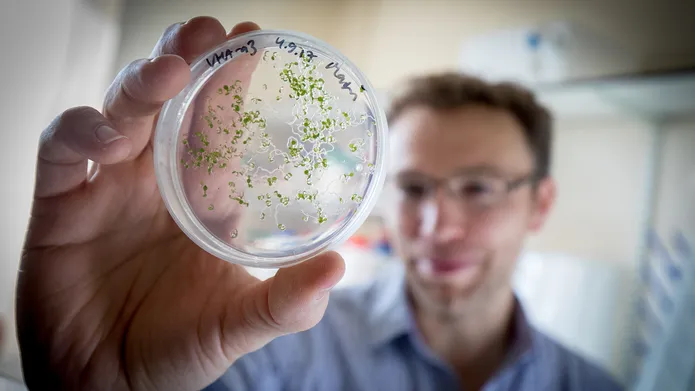
a blurred figure holding a petri dish containing cells

Feature
Innovations in Plant Sciences
Crop genomics for food security, sustaining human and environmental health
Published on 16 June 2021

Our health and that of our environment depends on plants. They produce the oxygen we breath, the food we eat, and the fossil reserves we currently depend on for our energy and industry. Understanding how best to use plants in the future is essential to feeding an increasing world population while mitigating climate change and protecting the biodiversity that contributes to our wellbeing. Our plant scientists in partnership with crop researchers at the James Hutton Institute (JHI), research the genetic make-up, or genome, of plants to identify the genes that are important to key traits like grain yield, disease resistance, or industrial properties, so that the ideal version of these genes can be used in crop breeding programmes.
The future of high-quality cereal crops
Professor Robbie Waugh led the UK team behind the decade-long international effort to fully sequence the genome of barley. The work, completed in 2017, revealed the location and structure of more than 39,000 genes and was a challenging undertaking since the barley genome is almost twice the size of the human genome and has more complex highly-repeated sequences. Barley is the world’s fourth most important cereal crop and the second most important UK crop, underpinning a £20 billion beer and whisky industry as well as feeding livestock and poultry and use in foodstuffs. Having a fully ordered genome sequence greatly helped Waugh and colleagues to locate and identify the genes influencing key traits.
For example, he has identified genes that are crucial to the reassortment of traits when plants are crossed, and others that are important to grain malting. Dundee colleagues have used his genetic and genomic tools to discover genes that control grain yield and quality as well as heat and climate-stress resiliency (McKim lab), genes important to aphid susceptibility and resistance (Bos lab), genes influencing barley straw industrial uses (Halpin lab), and genes that determine which microbes live near the crop’s roots and support its yield and health (Bulgarelli lab). Through active collaboration with the commercial sector, these discoveries can be used in practical crop improvement to produce better yielding more climate resilient varieties.
From the genome sequence of one barley variety in 2017, Waugh and collaborators rapidly progressed to the complete genome sequencing of 20 very different barleys, representing the global diversity in the crop. His current work involves hundreds of barley varieties from Ethiopia, one of the centres of barley domestication and biodiversity and a country where barley is a staple food. He is using his barley genomic resources to explore the micronutrient content of Ethiopian barley and identifying genes that will help increase essential health-promoting nutrients in the crop. Waugh now directs the research of new International Barley Hub (IBH), the major £35m Tay Cities Deal investment by the UK and Scottish Governments. IBH will facilitate the development of new barley varieties that can cope with climate change and support sustainable new uses for the crop, ensuring the long-term future of the barley sector.
James Brosnan, Director at The Scotch Whisky Research Institute and IBH Chairman
Regional Food Security with Indigenous Crops
Genome sequencing is also helping to increase the understanding of less well-known indigenous crops that are often critical to regional food security and well-adapted to local conditions, but that receive little study. Professor Gordon Simpson is using new technology - Nanopore direct RNA sequencing - to help analyse the genomes of key orphan crops in collaboration with the African Orphan Crop Consortium, the Rajiv Gandhi Biotechnology Centre in India, and University of Malaya in Malaysia. The team has already released the annotated genome of water yam and Simpson is continuing work on shea and black pepper that has important implications for food security and trade in countries and regions reliant on these crops.
Genome sequencing for healthier potato harvests
Similarly, genomic tools underpin work in Dundee on diseases of potato and related crops. Potato is one of the world’s most important non-cereal crops, but yields are reduced by 20-40% each year by late blight and other prevalent pathogens such as potato cyst nematodes and viruses. Professor Paul Birch aims to understand how late blight gets established and to identify genes and biological processes that can be exploited for its control. Dr Ingo Hein has developed genomic tools to identify and sequence variants of likely resistance genes. Using Resistance gene enrichment Sequencing (RenSeq), developed in collaboration with researchers at the Sainsbury Laboratory in Norwich, he has tracked the historical and geographical patterns of resistance genes in established potato varieties. His data suggests that limited genetic diversity in most potato varieties has left them vulnerable to diseases, and he has identified new and effective resistance genes in wild potato species that are currently being introduced to breed resilient potatoes and reduce the need for environmentally hazardous and expensive chemical sprays.
The Advanced Plant Growth Centre
Our barley and potato research will benefit from the new Advanced Plant Growth Centre established with a further £27m Tay Cities Deal investment at the JHI. This will provide state-of-the-art controlled environment plant growing facilities, enabling our researchers to better evaluate the effects of climate change on crops and their pathogens and contribute to a more sustainable future agriculture supporting human and environmental health.
For further information or to engage with our research, please contact: